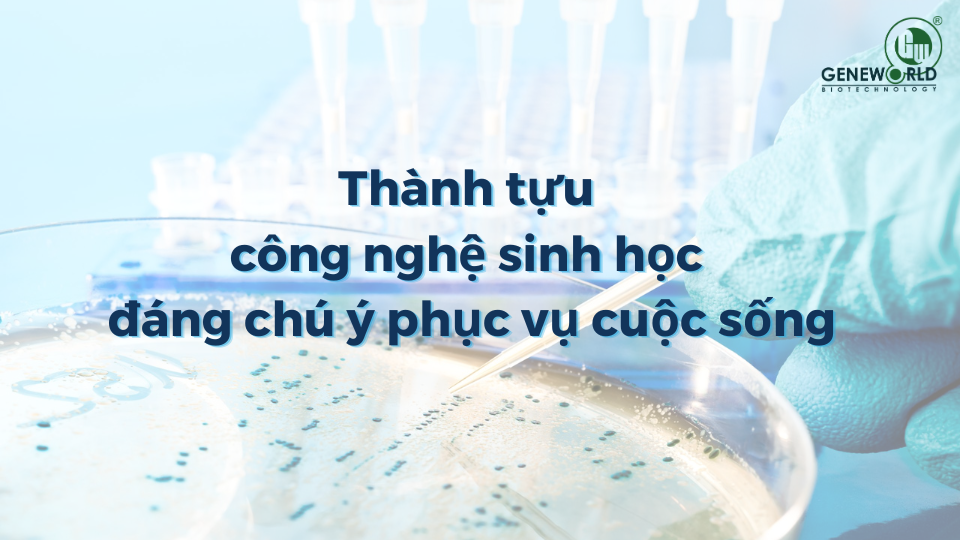

Thành tựu công nghệ sinh học đáng chú ý phục vụ cuộc sống
Với sự bùng nổ của công nghệ 4.0, nền công nghệ sinh học đã phát triển vượt bậc và mang lại nhiều thành tựu công nghệ sinh học đáng chú ý, có tác động tích cực đến cuộc sống con người. Những ứng dụng của công nghệ này đã có sự đóng góp quan trọng trong nhiều lĩnh vực, trong đó phải kể đến y tế, nông nghiệp, môi trường và làm đẹp. Từ đó, mở ra hy vọng cho một tương lai tốt đẹp hơn cho cuộc sống và hứa hẹn sẽ tiếp tục phát triển bùng nổ trong tương lai. Trong bài viết này, hãy cùng Geneworld tìm hiểu về một số thành tựu đáng chú ý của công nghệ sinh học và cách chúng đã phục vụ cho cuộc sống của con người.
Thành tựu công nghệ sinh học trong y học
Công nghệ sinh học đã mang đến rất nhiều thành tựu quan trọng trong lĩnh vực y học, giúp cải thiện chẩn đoán, điều trị và phòng ngừa nhiều loại bệnh tật nguy hiểm. Dưới đây là một số thành tựu đáng chú ý của công nghệ sinh học trong y học:
Giải mã gen: Công nghệ giải mã gen đã cho phép các nhà khoa học tìm hiểu về các gen lặn/trội và cơ chế di truyền của bệnh tật. Điều này giúp cho việc phát hiện và điều trị các bệnh di truyền trở nên dễ dàng hơn.
Y tế tùy chỉnh phù hợp với từng người bệnh: Nhờ vào khả năng phân tích dữ liệu gen của bệnh nhân, công nghệ sinh học giúp cho các nhà y tế dễ dàng tìm ra phương pháp điều trị tốt nhất cho từng trường hợp cụ thể.
Tế bào gốc: Công nghệ tế bào gốc đang được sử dụng để chữa trị các bệnh ung thư, bệnh tim mạch và các bệnh khác. Các tế bào này có khả năng tự tái tạo và biến đổi thành các tế bào khác trong cơ thể.
Công nghệ sinh học 3D: Công nghệ in 3D đã được sử dụng để tạo ra các mô học và các bộ phận cơ thể nhằm giúp các bác sĩ phát hiện và điều trị các bệnh tật một cách chính xác hơn.
Vaccine: Công nghệ sinh học giúp cho việc nghiên cứu và phát triển các loại vaccine phòng bệnh trở nên nhanh chóng và hiệu quả hơn. Các vaccine này đã góp phần quan trọng ngăn ngừa nhiều loại bệnh truyền nhiễm điển hình như COVID-19 cứu sống hàng triệu người trên thế giới.
Các thành tựu trên chỉ là một phần trong những đóng góp của công nghệ sinh học trong y học. Các nhà khoa học đang tiếp tục nghiên cứu và phát triển các công nghệ mới để giúp cải thiện sức khỏe và chất lượng cuộc sống của con người.
Thành tựu công nghệ sinh học trong nông nghiệp
Công nghệ sinh học đã có nhiều ứng dụng quan trọng trong lĩnh vực nông nghiệp, giúp tăng năng suất và hiệu quả sản xuất, bảo vệ môi trường và nâng cao giá trị sản phẩm. Dưới đây là một số thành tựu đáng chú ý của công nghệ sinh học trong nông nghiệp:
- Tạo giống mới: Công nghệ sinh học cho phép các nhà nghiên cứu tìm hiểu về gen của các loài cây và động vật để cải thiện chất lượng và sản lượng như mong muốn: siêu nạc, nhiều sữa, nhiều hoa... mang lại hiệu quả kinh tế cao. Đồng thời, các loại cây và động vật được tạo ra bằng công nghệ gen thường có khả năng chịu đựng tốt hơn đối với môi trường và bệnh tật.
- Nuôi cấy tế bào: Công nghệ nuôi cấy tế bào đang được sử dụng để sản xuất các loại thực phẩm và sản phẩm nông nghiệp không cần đất, nước và ánh sáng mặt trời. Từ đó góp phần làm giảm thiểu sự lãng phí tài nguyên và bảo vệ môi trường.
- Vaccine vật nuôi: Nhờ vào công nghệ sinh học, các nhà nghiên cứu đã phát triển được nhiều loại vaccine phòng tránh và điều trị một số loại bệnh trên vật nuôi, giảm nguy cơ bệnh và tiết kiệm được chi phí chăn nuôi cho người nông dân.
- Thuốc bảo vệ thực vật, chế phẩm sinh học: Nhiều chế phẩm thuốc bảo vệ thực vật sinh học được ứng dụng rộng rãi để trừ sâu khoang, sâu xanh hại rau màu. Những chế phẩm này giúp người nông dân hạn chế tác hại của sâu bệnh, chuột… và cải thiện năng suất, chất lượng cây trồng.
Từ những thông tin trên có thể thấy vai trò và thành tựu công nghệ sinh học trong nông nghiệp, mang lại nhiều giá trị tích cực cho sự phát triển kinh tế - xã hội.
Thành tựu công nghệ sinh học trong làm đẹp
Công nghệ sinh học đã mang lại nhiều ứng dụng đáng chú ý trong lĩnh vực làm đẹp, cải thiện chất lượng và hiệu quả của các sản phẩm làm đẹp, đồng thời giảm thiểu tác động tiêu cực đến môi trường và sức khỏe của con người.
An toàn cho da: Mỹ phẩm công nghệ sinh học hướng đến việc làm đẹp bền vững từ bên trong, tái cấu trúc và phục hồi chức năng của tế bào, mang lại khả năng ưu việt trong việc sửa chữa thương tổn trên da. Đồng thời, mỹ phẩm sinh học cũng được đánh giá cao nhờ quy tắc 5 KHÔNG: Không chất bảo quản, không Silicone, không dầu khoáng, không chất nhũ hóa, không màu và hương thơm nhân tạo.
- Công nghệ tế bào gốc: Công nghệ tế bào gốc đang được sử dụng để sản xuất các sản phẩm làm đẹp có khả năng tái tạo và tái sinh da. Các sản phẩm này giúp cải thiện độ đàn hồi và độ mịn của da, giảm thiểu nếp nhăn và cho làn da trẻ trung hơn.
- Công nghệ gen: Công nghệ gen đã cho phép các nhà nghiên cứu tìm hiểu về các gen liên quan đến làn da và tóc. Các sản phẩm làm đẹp được tạo ra bằng công nghệ gen thường có khả năng chống lão hóa và tăng cường sức khỏe cho tóc và da.
- Duy trì sinh thái tự nhiên: Công nghệ sinh học sử dụng các quá trình sinh học và lên men vi sinh vật từ nguyên liệu thiên nhiên, tảo, enzyme, vi khuẩn và nấm men để sản xuất ra mỹ phẩm. Các thành phần này mang tính tái tạo, duy trì tính bền vững của hệ sinh thái.
Với những thành tựu công nghệ sinh học trong lĩnh vực làm đẹp này hứa hẹn sẽ mang tới cho ngành làm đẹp những bứt phá mới. Các nhà khoa học sẽ còn nghiên cứu và phát triển thêm nhiều công nghệ mới để nâng cao chất lượng và hiệu quả của các sản phẩm làm đẹp.
Là thương hiệu tiên phong trong việc ứng dụng công nghệ sinh học trong mỹ phẩm làm đẹp, Geneworld đã mang tới những sản phẩm chất lượng, được phân phối rộng khắp các Spa, thẩm mỹ viện và phòng khám da liễu trên toàn quốc. Toàn bộ sản phẩm của Geneworld đều được nghiên cứu bởi đội ngũ khoa học hàng đầu, ứng dụng công nghệ sinh học hiện đại để cho ra thành phẩm cuối cùng đạt chất lượng kiểm định phục vụ cho ngành làm đẹp an toàn. Một số dòng sản phẩm nổi bật của công ty gồm: Dịch chiết tế bào gốc nhung hươu Medigen, bộ sản phẩm hữu cơ Bio, bộ sản phẩm lên men vi sinh Microbiome… Có thể nói, Geneworld là đơn vị ứng dụng thành tựu công nghệ sinh học vào làm đẹp rất thành công.
Thành tựu công nghệ sinh học trong bảo vệ môi trường
Công nghệ sinh học đã mang lại nhiều ứng dụng quan trọng trong lĩnh vực bảo vệ môi trường, giúp giảm thiểu tác động tiêu cực của con người đến môi trường tự nhiên và bảo vệ các nguồn tài nguyên quý giá trên hành tinh. Dưới đây là một số thành tựu đáng chú ý của công nghệ sinh học trong bảo vệ môi trường:
Xử lý nước thải: Sản phẩm ứng dụng công nghệ sinh học được sử dụng để xử lý nước thải và giảm thiểu chất độc hại có trong nước. Các hệ thống xử lý nước thải bằng công nghệ sinh học có thể giúp giảm thiểu sự ô nhiễm môi trường và bảo vệ các nguồn tài nguyên nước.
Công nghệ sinh học tái chế: Công nghệ sinh học tái chế giúp giảm thiểu lượng rác thải được sản xuất và tạo ra các sản phẩm tái chế từ các vật liệu tái sử dụng. Điều này giúp giảm thiểu tác động của rác thải đến môi trường, đồng thời giảm thiểu sự lãng phí tài nguyên.
Tận dụng chất thải: Phụ phẩm là phân vật nuôi heo, gà, bò, rác thải sinh hoạt… được tận dụng để làm khí đốt Biogas; rác thải, than bùn... đã qua xử lý bằng công nghệ sinh học được tận dụng làm phân bón cho cây trồng; từ đó, tiết kiệm được rất nhiều chi phí và sử dụng có hiệu quả nguồn chất thải, góp phần bảo vệ môi trường.
Chung quy lại, công nghệ sinh học đã đem tới những thành tựu vượt trội, hỗ trợ nâng cao chất lượng sống của con người từ việc cải thiện sức khỏe, chăm sóc sắc đẹp, phát triển nền nông nghiệp đến bảo vệ môi trường. Với sự phát triển không ngừng của công nghệ sinh học, chúng ta có thể hy vọng vào những thành tựu công nghệ sinh học mới. Để tìm hiểu thêm về dòng mỹ phẩm công nghệ sinh học, truy cập Geneworld ngay bạn nhé.
Bài viết liên quan
PRP treatment là gì? Ứng dụng PRP treatment trong lành vết thương
Trong y học tái tạo hiện đại, PRP treatment đang ngày càng được quan tâm nhờ khả năng hỗ trợ phục hồi nhanh chóng các mô tổn thương. Không chỉ được ứng dụng rộng rãi trong da liễu, thẩm mỹ hay chấn...
PRP da mặt: Tác dụng, quy trình thực hiện và bộ KIT chuẩn y khoa
PRP da mặt là phương pháp làm đẹp sử dụng máu tự thân an toàn, hiệu quả từ gốc. Không chỉ giúp cải thiện sắc tố, làm mờ nếp nhăn, PRP còn hỗ trợ tái tạo Collagen, mang lại làn da căng bóng, khỏe đẹ...
Khi nào cần thải độc da mặt? Gợi ý sản phẩm thải độc da mặt tại nhà
Làn da mỗi ngày phải đối mặt với bụi bẩn, vi khuẩn, ánh nắng và lớp trang điểm, khiến độc tố dễ tích tụ, gây ra tình trạng xỉn màu, nổi mụn, lỗ chân lông to. Đây chính là tác nhân cảnh báo cần phải...